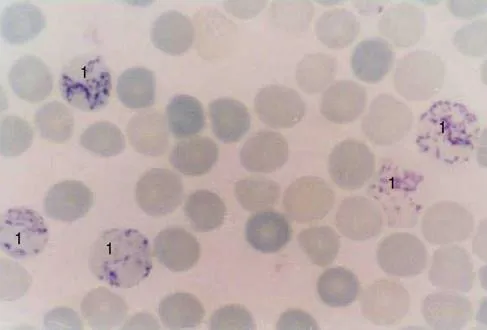
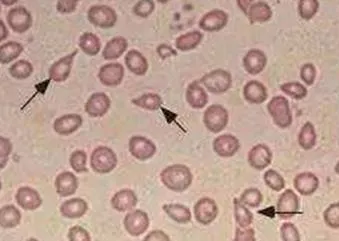
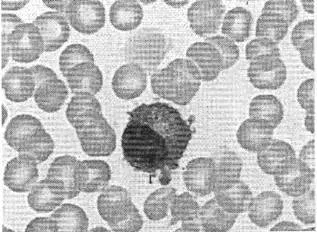
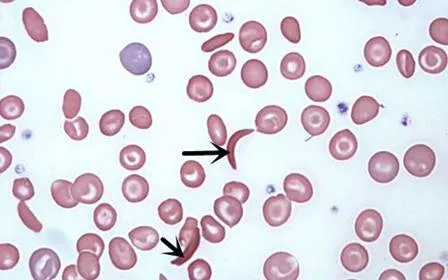

2026年初中级备考-今日10题
1.血涂片煌焦油蓝染色如图所示,标记序号1所指细胞为( )。
A.中性粒细胞
B.单核细胞
C.淋巴细胞
D.网织红细胞
E.嗜碱性点彩红细胞
【答案】D
【解析】
煌焦油蓝染色是网织红细胞特异性染色方法,网织红细胞内RNA的磷酸基带有负电荷,能与碱性染料煌焦油蓝带正电荷的有色反应基团结合,形成核酸与碱性染料复合物的多聚体,呈深染的颗粒状或网状结构。凡含两个以上的深染颗粒或具有线网状结构的无核红细胞,即为网织红细胞。
2.如图所示,图中箭头所指细胞为( )。
A.鳞状上皮细胞
B.粗颗粒管型
C.吞噬细胞
D.淋巴细胞
E.红细胞

【答案】C
【解析】
吞噬细胞具有吞噬衰老细胞和异物的功能,细胞体积大,胞质丰富,核圆形、卵圆形或肾形,略偏位,染色质均匀细致,偶见核仁,图为吞噬细胞。
3.血涂片如图所示,图片箭头所指细胞为( )。
A.裂细胞
B.泪滴形红细胞
C.靶形红细胞
D.棘细胞
E.镰形细胞
【答案】B
【解析】
泪滴形红细胞即形如泪滴样或梨状的红细胞,见于贫血、骨髓纤维化和正常人。
4.患者男,55岁,因骨痛就诊,CBC发现:WBC 7.3×109/L,HGB90g/L,血涂片如图所示,所见成分是( )。
A.淋巴细胞
B.单核细胞
C.幼稚细胞
D.有核红细胞
E.浆细胞
【答案】E
【解析】
浆细胞:胞体直径8~15pm,圆形或椭圆形。胞核明显缩小,较圆,可占细胞1/3以下,偏于细胞一侧,核的外侧常有明显的淡染区,核染色质浓密成块,常排列成车轮状,无核仁。外周血出现浆细胞、贫血伴骨痛,符合多发性骨髓瘤的诊断。
5.血涂片如图所示,箭头所指细胞为( )。
A.镰形红细胞
B.泪滴红细胞
C.裂片红细胞
D.棘红细胞
E.刺红细胞
【答案】A
【解析】
镰形红细胞:细胞呈镰刀状、线条状或L、S、V形等,是含有异常血红蛋白S(HbS)的红细胞。见于镰状细胞贫血、镰状细胞特性样本。
6.POX阳性最强的是( )。
A.FAB-M4
B.FAB-M2
C.FAB-M3
D.FAB-M5
E.FAB-M1
【答案】C
【解析】
过氧化物酶(POX)染色:分化差的原始粒细胞为阴性,分化好的原始粒细胞至中性成熟粒细胞均呈阳性。随细胞的成熟,阳性反应的程度逐渐增强。选项中急性髓系白血病FAB-M1、FAB-M2、FAB-M3以粒细胞增生为主,其中FAB-M3分化程度最高,POX阳性最强。
7.酶免疫组织化学最常用的酶是( )。
A.胰蛋白酶
B.胃蛋白酶
C.乳酸脱氢酶
D.辣根过氧化物酶
E.蛋白酶K
【答案】D
【解析】
辣根过氧化物酶(HRP),来源于蔬菜植物辣根,是由无色的糖蛋白(主酶)和亚铁血红素(辅基)结合而成的复合物,是免疫组织化学的首选用酶。
8.患者,面部红斑成蝶状,特异性的确诊检查为( )。
A.抗CCP抗体+抗Sd-70抗体
B.抗CCP抗体+抗ds-DNA抗体
C.抗Sm抗体+抗CCP抗体
D.抗Sd-70抗体+抗ds-DNA抗体
E.抗ds-DNA抗体+抗Sm抗体
【答案】E
【解析】
患者面部红斑成蝶状,首先怀疑为系统性红斑狼疮(SLE),应选抗ds-DNA抗体+抗Sm抗体检查。其中,抗ds-DNA抗体是SLE患者的特征性标志抗体,该抗体阳性为SLE的重要诊断标准之一。抗Sm抗体仅发现于SLE患者中,也是SLE的血清标志抗体。
9.结核性脑膜炎的脑脊液外观呈( )。
A.白色明显浑浊
B.深棕褐色浑浊
C.黄色浑浊
D.毛玻璃样轻度浑浊
E.清晰透明
【答案】D
【解析】
结核性脑膜炎脑脊液呈毛玻璃样微混,静置12~24h,表面有薄膜或纤维凝块。该薄膜或凝块做结核分枝杆菌检查,阳性检出率高。
10.亚急性心内膜炎最常见的致病菌是( )。
A.草绿色链球菌
B.无乳链球菌
C.金黄色葡萄球菌
D.化脓性链球菌
E.真菌
【答案】A
【解析】
草绿色链球菌是人体的正常菌群之一,分布于口腔、上呼吸道胃肠道和阴道等处,是亚急性心内膜炎的主要病原菌。
